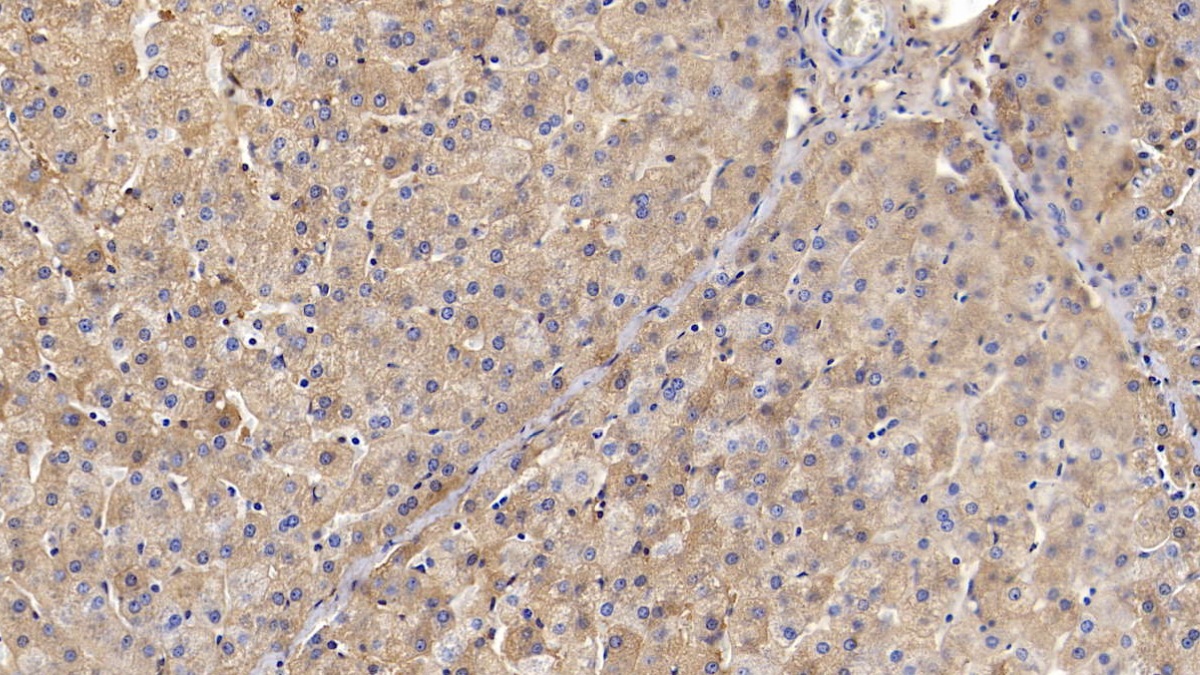
https://d1vffmuvmgkypt.cloudfront.net/image/ridacom_ltd/cloud_clone_corp/PRODUCT_SOURCE__CLOUD_CLONE__SUPPLIER__RIDACOM__ID__PAC036Po01__1

Antigen
TF
Isotype
IgG1
(16)
IgG
(3)
IgG2b
(2)
Reactivity
Human
(29)
Mouse
(10)
Rat
(10)
Pig
(6)
Wild boar
(6)
Cattle
(5)
Preparation method
Escherichia coli
(7)
Cattle
(1)
Human
(1)
Pig
(1)
Research area
Immune molecule
(32)
Infection immunity
(32)
Tumor immunity
(32)
Clonality
Monoclonal
(18)
Polyclonal
(10)
Application
Sort
Western Blotting
(38)
Immunocytochemistry
(22)
Immunohistochemistry
(22)
IHC-P
(16)
ELISA
(14)
Immunoprecipitation
(11)
Positive Control
(10)
SDS-PAGE
(10)
Immunofluorescence
(6)
Enzyme-linked immunosorbent assay for Antigen Detection
(5)
Chemiluminescent immunoassay for antigen detection
(2)
Supplier
Cloud-Clone Corp.
(39)
Abbkine Scientific Co., Ltd.
(21)
Affinity Biosciences
(1)
Test method
Double-antibody Sandwich
(6)
Colorimetric
(5)
Competitive Inhibition
(1)
Host
Mouse
(18)
Rabbit
(10)
CHO
(6)
293F
(5)
Category
Antibodies
(39)
ELISA Kits
(12)
Cell biology
(10)
Immunochemicals
(10)
Protein Biochemistry
(10)

Antigen:
Reactivity:Rat
Application:Chemiluminescent immunoassay for Antigen Detection
Test method:Double-antibody Sandwich
| 48T | $638.00 | |
| 96T | $912.00 | |
| 96T*5 | $4,104.00 |
| 96T*10 | $7,752.00 | |
| 96T*100 | $63,840.00 |

Antigen:
Reactivity:Human
Application:Chemiluminescent immunoassay for Antigen Detection
Test method:Double-antibody Sandwich
| 48T | $588.00 | |
| 96T | $840.00 | |
| 96T*5 | $3,780.00 |
| 96T*10 | $7,140.00 | |
| 96T*100 | $58,800.00 |

Antigen:
Reactivity:Rat
Application:Enzyme-linked immunosorbent assay for Antigen Detection
Test method:Double-antibody Sandwich
| 48T | $372.00 | |
| 96T | $532.00 | |
| 96T*5 | $2,394.00 |
| 96T*10 | $4,522.00 | |
| 96T*100 | $37,240.00 |

Antigen:
Reactivity:Human
Application:Enzyme-linked immunosorbent assay for Antigen Detection
Test method:Double-antibody Sandwich
| 48T | $328.00 | |
| 96T | $469.00 | |
| 96T*5 | $2,111.00 |
| 96T*10 | $3,987.00 | |
| 96T*100 | $32,830.00 |

Antigen:
Reactivity:Mouse
Application:Enzyme-linked immunosorbent assay for Antigen Detection
Test method:Double-antibody Sandwich
| 48T | $315.00 | |
| 96T | $450.00 | |
| 96T*5 | $2,025.00 |
| 96T*10 | $3,825.00 | |
| 96T*100 | $31,500.00 |

Antigen:
Reactivity:Human
Application:Enzyme-linked immunosorbent assay for Antigen Detection
Test method:Double-antibody Sandwich
| 48T | $293.00 | |
| 96T | $419.00 | |
| 96T*5 | $1,886.00 |
| 96T*10 | $3,562.00 | |
| 96T*100 | $29,330.00 |

Antigen:
Reactivity:Mouse
Application:Enzyme-linked immunosorbent assay for Antigen Detection
Test method:Competitive Inhibition
| 48T | $279.00 | |
| 96T | $398.00 | |
| 96T*5 | $1,791.00 |
| 96T*10 | $3,383.00 | |
| 96T*100 | $27,860.00 |
Native Transferrin (TRF)
$144.00

Antigen:
Transferrin
Synonyms: TF; Siderophilin; Serotransferrin; Beta-1 metal-binding globulin
Reactivity:Cattle
Application:Positive Control; SDS-PAGE; Western Blotting
Research area:Tumor immunity; Infection immunity; Immune molecule
Preparation method:Cattle
| 10µg | $144.00 | |
| 50µg | $360.00 | |
| 200µg | $720.00 |
| 1mg | $2,160.00 | |
| 5mg | $5,400.00 |

Antigen:
Transferrin
Synonyms: TF; Siderophilin; Serotransferrin; Beta-1 metal-binding globulin
Host:293F
Reactivity:Wild boar; Pig
Application:Western Blotting; Immunohistochemistry; Immunocytochemistry; Immunofluorescence
Research area:Tumor immunity; Infection immunity; Immune molecule
| 20µl | $151.00 | |
| 100µl | $353.00 | |
| 200µl | $504.00 |
| 1ml | $1,260.00 | |
| 10ml | $5,040.00 |

Antigen:
Transferrin
Synonyms: TF; Siderophilin; Serotransferrin; Beta-1 metal-binding globulin
Reactivity:Cattle
Application:Positive Control; SDS-PAGE; Western Blotting
Research area:Tumor immunity; Infection immunity; Immune molecule
Preparation method:Escherichia coli
| 10µg | $140.00 | |
| 50µg | $350.00 | |
| 200µg | $700.00 |
| 1mg | $2,100.00 | |
| 5mg | $5,250.00 |

Antigen:
Transferrin
Synonyms: TF; Siderophilin; Serotransferrin; Beta-1 metal-binding globulin
Host:CHO
Reactivity:Wild boar; Pig
Application:Western Blotting; Immunohistochemistry; Immunocytochemistry
Research area:Tumor immunity; Infection immunity; Immune molecule
| 20µl | $139.00 | |
| 100µl | $323.00 | |
| 200µl | $462.00 |
| 1ml | $1,155.00 | |
| 10ml | $4,620.00 |

Antigen:
Transferrin
Synonyms: TF; Siderophilin; Serotransferrin; Beta-1 metal-binding globulin
Host:CHO
Reactivity:Cattle
Application:Western Blotting; Immunohistochemistry; Immunocytochemistry
Research area:Tumor immunity; Infection immunity; Immune molecule
| 20µl | $139.00 | |
| 100µl | $323.00 | |
| 200µl | $462.00 |
| 1ml | $1,155.00 | |
| 10ml | $4,620.00 |

Antigen:
Transferrin
Synonyms: TF; Siderophilin; Serotransferrin; Beta-1 metal-binding globulin
Host:Mouse
Reactivity:Wild boar; Pig
Application:Western Blotting; Immunohistochemistry; Immunocytochemistry; Immunoprecipitation
Isotype:IgG2b
Clonality:Monoclonal
Research area:Tumor immunity; Infection immunity; Immune molecule
| 20µl | $132.00 | |
| 100µl | $308.00 | |
| 200µl | $440.00 |
| 1ml | $1,100.00 | |
| 10ml | $4,400.00 |
Native Transferrin (TRF)
$120.00

Antigen:
Transferrin
Synonyms: TF; Siderophilin; Serotransferrin; Beta-1 metal-binding globulin
Reactivity:Wild boar; Pig
Application:Positive Control; SDS-PAGE; Western Blotting
Research area:Tumor immunity; Infection immunity; Immune molecule
Preparation method:Pig
| 10µg | $120.00 | |
| 50µg | $300.00 | |
| 200µg | $600.00 |
| 1mg | $1,800.00 | |
| 5mg | $4,500.00 |
Antigen:
Transferrin
Synonyms: TF; Siderophilin; Serotransferrin; Beta-1 metal-binding globulin
Host:Rabbit
Reactivity:Wild boar; Pig
Application:Western Blotting; Immunohistochemistry; Immunocytochemistry; Immunoprecipitation
Clonality:Polyclonal
Research area:Tumor immunity; Infection immunity; Immune molecule
| 20µl | $126.00 | |
| 100µl | $294.00 | |
| 200µl | $420.00 |
| 1ml | $1,050.00 | |
| 10ml | $4,200.00 |

Antigen:
Transferrin
Synonyms: TF; Siderophilin; Serotransferrin; Beta-1 metal-binding globulin
Host:Rabbit
Reactivity:Cattle
Application:Western Blotting; Immunohistochemistry; Immunocytochemistry; Immunoprecipitation
Clonality:Polyclonal
Research area:Tumor immunity; Infection immunity; Immune molecule
| 20µl | $126.00 | |
| 100µl | $294.00 | |
| 200µl | $420.00 |
| 1ml | $1,050.00 | |
| 10ml | $4,200.00 |

Antigen:
Transferrin
Synonyms: TF; Siderophilin; Serotransferrin; Beta-1 metal-binding globulin
Host:Rabbit
Reactivity:Cattle
Application:Western Blotting; Immunohistochemistry; Immunocytochemistry; Immunoprecipitation
Isotype:IgG
Clonality:Polyclonal
Research area:Tumor immunity; Infection immunity; Immune molecule
| 20µl | $126.00 | |
| 100µl | $294.00 | |
| 200µl | $420.00 |
| 1ml | $1,050.00 | |
| 10ml | $4,200.00 |

Antigen:
Serotransferrin
Synonyms: Beta-1 metal-binding globulin; Siderophilin; TRFE_PIG; P09571
Test method:Colorimetric
serotransferrin is a member of transferrin family. TF (transferrin) is a 80kDa monomeric blood plasma glycoprotein with iron bindinding property. It is braodly divded into two regions with two iron binding sites. Both the N-terminal and C-terminal domains consist of two sub domains (N1 and N2, C1 and C2) connected by a hinge region.
| 48T | $280.00 | |
| 96T | $480.00 |
| 96T*5 | $2,160.00 | |
| 96T*50 | $20,160.00 |

Antigen:
Serotransferrin
Synonyms: Beta-1 metal-binding globulin; Siderophilin; TRFE_RABIT; O46514; P19134
Test method:Colorimetric
Transferrins are iron-binding blood plasma glycoproteins that control the level of free iron (Fe) in biological fluids.Transferrin glycoproteins bind iron tightly, but reversibly. The affinity of transferrin for Fe(III) is extremely high (association constant is 1020 M−1 at pH 7.4) but decreases progressively with decreasing pH below neutrality.
| 48T | $280.00 | |
| 96T | $480.00 |
| 96T*5 | $2,160.00 | |
| 96T*50 | $20,160.00 |

Antigen:
Serotransferrin
Synonyms: Beta-1 metal-binding globulin; Siderophilin; TRFE_RABIT; O46514; P19134
Test method:Colorimetric
plays a role iin iron transport and homeostasis [RGD, Feb 2006]
| 48T | $280.00 | |
| 96T | $480.00 |
| 96T*5 | $2,160.00 | |
| 96T*50 | $20,160.00 |

Antigen:
Serotransferrin
Synonyms: Beta-1 metal-binding globulin; Siderophilin; TRFE_HUMAN; O43890; P02787; Q1HBA5; Q9NQB8; Q9UHV0
Test method:Colorimetric
Transferrin (TF) is a glycoprotein with an approximate molecular weight of 76.5 kDa. It is thought to have been created as a result of an ancient gene duplication event that led to generation of homologous C and N-terminal domains each of which binds one ion of ferric iron. The function of Transferrin (TF) is to transport iron from the intestine, reticuloendothelial system, and liver parenchymal cells to all proliferating cells in the body. Transferrin (TF) may also have a physiologic role as granulocyte/pollen-binding protein (GPBP) involved in the removal of certain organic matter and allergens from serum.
| 48T | $280.00 | |
| 96T | $480.00 |
| 96T*5 | $2,160.00 | |
| 96T*50 | $20,160.00 |

Antigen:
Serotransferrin
Synonyms: Beta-1 metal-binding globulin; Siderophilin; TRFE_BOVIN; Q0IIK2; Q29443
Test method:Colorimetric
Transferrins are iron binding transport proteins which can bind two Fe3+ ions in association with the binding of an anion, usually bicarbonate. It is responsible for the transport of iron from sites of absorption and heme degradation to those of storage and utilization. Serum transferrin may also have a further role in stimulating cell proliferation.
| 48T | $280.00 | |
| 96T | $480.00 |
| 96T*5 | $2,160.00 | |
| 96T*50 | $20,160.00 |

Antigen:
Transferrin
Synonyms: TF; Siderophilin; Serotransferrin; Beta-1 metal-binding globulin
Reactivity:Wild boar; Pig
Application:Positive Control; SDS-PAGE; Western Blotting
Research area:Tumor immunity; Infection immunity; Immune molecule
Preparation method:Escherichia coli
| 10µg | $112.00 | |
| 50µg | $280.00 | |
| 200µg | $560.00 |
| 1mg | $1,680.00 | |
| 5mg | $4,200.00 |
Native Transferrin (TRF)
$112.00

Antigen:
Transferrin
Synonyms: TF; Siderophilin; Serotransferrin; Beta-1 metal-binding globulin
Reactivity:Human
Application:Positive Control; SDS-PAGE; Western Blotting
Research area:Tumor immunity; Infection immunity; Immune molecule
Preparation method:Human
| 10µg | $112.00 | |
| 50µg | $280.00 | |
| 200µg | $560.00 |
| 1mg | $1,680.00 | |
| 5mg | $4,200.00 |



-SCC036Ra-000001.png)


-SCC036Hu-000001.png)


-SEC036Ra-000001.png)


-HEC036Hu-000001.png)


-HEC036Mu-000001.png)


-SEC036Hu-000001.png)


-CEC036Mu-000001.png)





-MAC036Po21-000001.png)

-NPC036Po01-000001.png)













-PAC036Bo02-000001.png)







